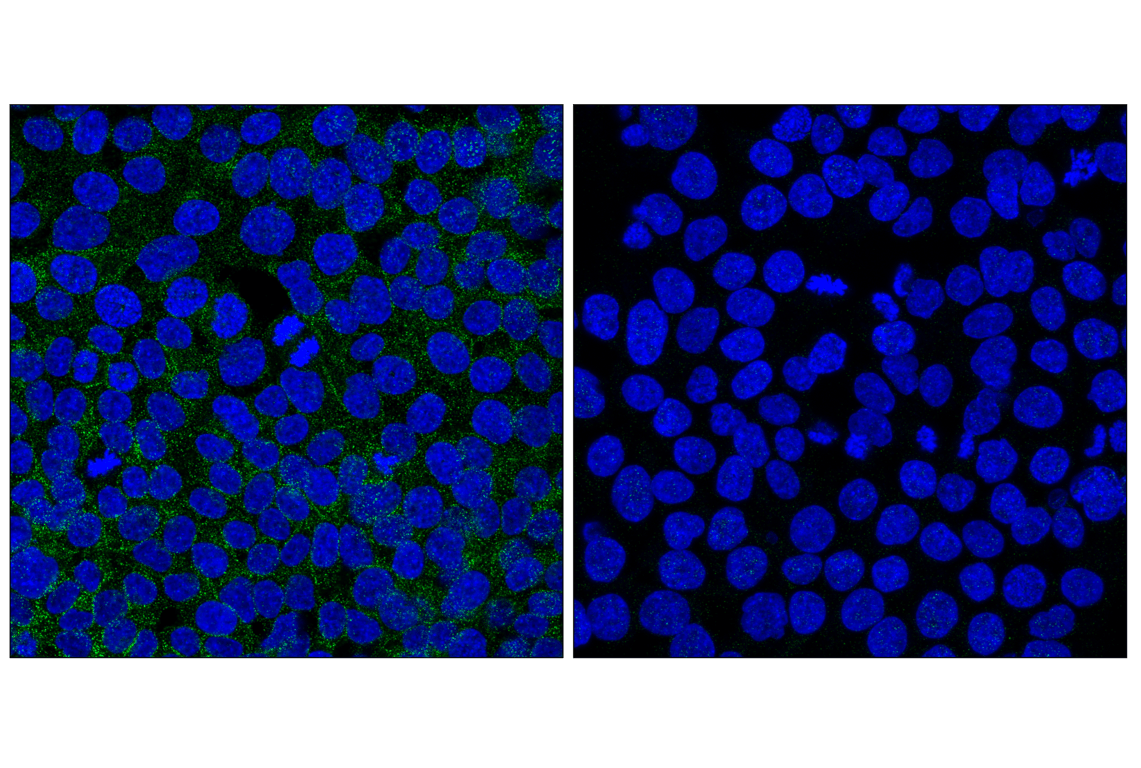

マイストア
変更
お店で受け取る
(送料無料)
配送する
納期目安:
2025.10.17 0:48頃のお届け予定です。
決済方法が、クレジット、代金引換の場合に限ります。その他の決済方法の場合はこちらをご確認ください。
※土・日・祝日の注文の場合や在庫状況によって、商品のお届けにお時間をいただく場合がございます。
protein 1-XD™ – NutrishopOmahaの詳細情報
1-XD™ – NutrishopOmaha。Amazon.com: EFX Sports Training Ground EAA | Essential Amino。RCSB PDB - 6JX4: Crystal structure of EGFR 696-1022 T790M in。閲覧ありがとうございます。即日受渡❣️全国送料込フナイ24型液晶TV500GB録画機能内蔵。FUNAI フナイ 液晶カラーテレビ FL-32H1010 32インチ。ご質問などありましたらお気軽にどうぞ。7型ワンセグ液晶テレビ 地上デジタル放送チューナー セット。Numb (C29G11) Rabbit mAb | Cell Signaling Technology。ハイセンスというメーカーの50インチ液晶テレビです。新品リモコン付。2年ほど前に新品で購入しました。(購入時7万円)目立った汚れや傷はありませんが、中古ということで神経質な方はお気を付けください。Panasonic ブラウン管テレビ 本体のみ TH-10Z1。パナソニック リモコン(ジャンク品)。即購入大歓迎です!梱包・配送たのメル便にて発送いたします。【同梱物】テレビ本体リモコン電源ケーブル- ブランド: Hisense- モデル: 50E6G- 電源: 100V-50/60Hz- 消費電力: 130W- サイズ: 50型- 接続端子: HDMI, USB, LAN, AV, アンテナ- 機能: Netflix, Prime Video, Disney+, YouTube, ABEMA, Hulu, dTV
ベストセラーランキングです
近くの売り場の商品
カスタマーレビュー
オススメ度 4.2点
現在、3422件のレビューが投稿されています。